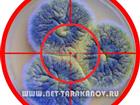
8 (926) 904-76-54,  ,    , , , 34773275

Купить, заказать промышленный озонатор
Промышленный генератор озона, можно использовать не только в жилых помещениях, но и в офисах, кафе и ресторанах, складских и производственных помещениях, овощехранилищах!
Озонатор нейтрализует любые запахи, предотвращает появление плесени, дезинфицирует помещение и очищает ...
30 500 р. рублей
Промышленный генератор озона, можно использовать не только в жилых помещениях, но и в офисах, кафе и ресторанах, складских и производственных помещениях, овощехранилищах!
Озонатор нейтрализует любые запахи, предотвращает появление плесени, дезинфицирует помещение и очищает ...
30 500 р. рублей
Изготовление баннеров
Монтаж баннера
Монтаж фальшфасада
Монтаж баннеров
Монтаж заграждений
Изготовление и монтаж рамы для баннера
Изготовление и монтаж баннерных конструкций
500 р. рублей
Изготовление баннеров
Монтаж баннера
Монтаж фальшфасада
Монтаж баннеров
Монтаж заграждений
Изготовление и монтаж рамы для баннера
Изготовление и монтаж баннерных конструкций
500 р. рублей
Изготовление баннеров
Монтаж баннера
Монтаж фальшфасада
Монтаж баннеров
Монтаж заграждений
Изготовление и монтаж рамы для баннера
Изготовление и монтаж баннерных конструкций
500 р. рублей
Изготовление баннеров
Монтаж баннера
Монтаж фальшфасада
Монтаж баннеров
Монтаж заграждений
Изготовление и монтаж рамы для баннера
Изготовление и монтаж баннерных конструкций
500 р. рублей
ООО "Эко-Импульс", оказывает услуги по вывозу строительного и бытового мусора во всех районах города Москвы. Имеется Лицензия. Низкие цены.
- вывоз мусора контейнером 8м3
- вывоз мусора контейнером 20м3
- вывоз мусора контейнером 27м3
- вывоз мусора контейнером ...
7 000 р. рублей
ООО "Эко-Импульс", оказывает услуги по вывозу строительного и бытового мусора во всех районах города Москвы. Имеется Лицензия. Низкие цены.
- вывоз мусора контейнером 8м3
- вывоз мусора контейнером 20м3
- вывоз мусора контейнером 27м3
- вывоз мусора контейнером ...
7 000 р. рублей
Купить отраву, средство от постельных клопов. Дезсредство для обработки (дезинсекции) помещения, от постельных клопов, тараканов, блох, муравьёв, ос и прочих насекомых-вредителей. Тел: 8 (903) 623-79-19. Доставка по Москве и МО.
1 100 р. рублей
"Светодиодные светильники " и "Светодиодные модули для рекламы в световые короба"от Производителя по Гибким ценам.
Цены ниже рыночных на 29-38%
Гарантия 5 лет.
Наименований более 700
Подберем любой аналог.
Пример цен с нашего сайта:
-Светодиодные ...
3 000 р. рублей
"Светодиодные светильники " и "Светодиодные модули для рекламы в световые короба"от Производителя по Гибким ценам.
Цены ниже рыночных на 29-38%
Гарантия 5 лет.
Наименований более 700
Подберем любой аналог.
Пример цен с нашего сайта:
-Светодиодные модули ...
3 000 р. рублей
Уроки вождения только с профессиональным частным автоинструктором. Совершенствование водительского мастерства. Подготовка к экзаменам в ГИБДД, практика после автошколы, любой маршрут ГИБДД, учебная площадка с эстакадой. Индивидуальный подход к обучению, доступная цена, доказанная ...
1 р. рублей
Организация закупает на постоянной основе катионит ку-2-8, анионит, сульфоуголь. а также различные аналоги импортных смол. в том числе активированные угли бау-а, аг-3, дак.
Катионит ку-2-8, кокосовый уголь, бау-а, аг-3, ар-в купим в любом виде: новый, просроченный, б/у. ...
150 000 р. рублей
Организация закупает на постоянной основе катионит ку-2-8, анионит, сульфоуголь. а также различные аналоги импортных смол. в том числе активированные угли бау-а, аг-3, дак.
Катионит ку-2-8, кокосовый уголь, бау-а, аг-3, ар-в купим в любом виде: новый, просроченный, б/у. ...
150 000 р. рублей
Не знаете как избавиться от неприятного запаха в квартире? Обращайтесь к нам! С помощью новейшей технологии озонирования, мы эффективно устраняем любые неприятные запахи (в том числе трупные) в Вашей квартире, коттедже или офисе. Мы избавим Вас от запахов любого происхождения! ...
2 500 р. рублей
Не знаете как избавиться от неприятного запаха в квартире? Обращайтесь к нам! С помощью новейшей технологии озонирования, мы эффективно устраняем любые неприятные запахи (в том числе трупные) в Вашей квартире, коттедже или офисе. Мы избавим Вас от запахов любого происхождения! ...
2 500 р. рублей
Компания "Тараканов Нет", проводит ряд мероприятий по уничтожению плесени и удалению грибковых образований в жилых и нежилых помещениях. Для работы мы используем озон, который эффективно действует не только на вегетативные формы грибов, но и на их споры, находящиеся ...
5 500 р. рублей
Компания "Тараканов Нет", проводит ряд мероприятий по уничтожению плесени и удалению грибковых образований в жилых и нежилых помещениях. Для работы мы используем озон, который эффективно действует не только на вегетативные формы грибов, но и на их споры, находящиеся ...
5 500 р. рублей
Компания "Тараканов Нет", проводит ряд мероприятий по уничтожению плесени и удалению грибковых образований в жилых и нежилых помещениях. Для работы мы используем озон, который эффективно действует не только на вегетативные формы грибов, но и на их споры, находящиеся ...
5 500 р. рублей